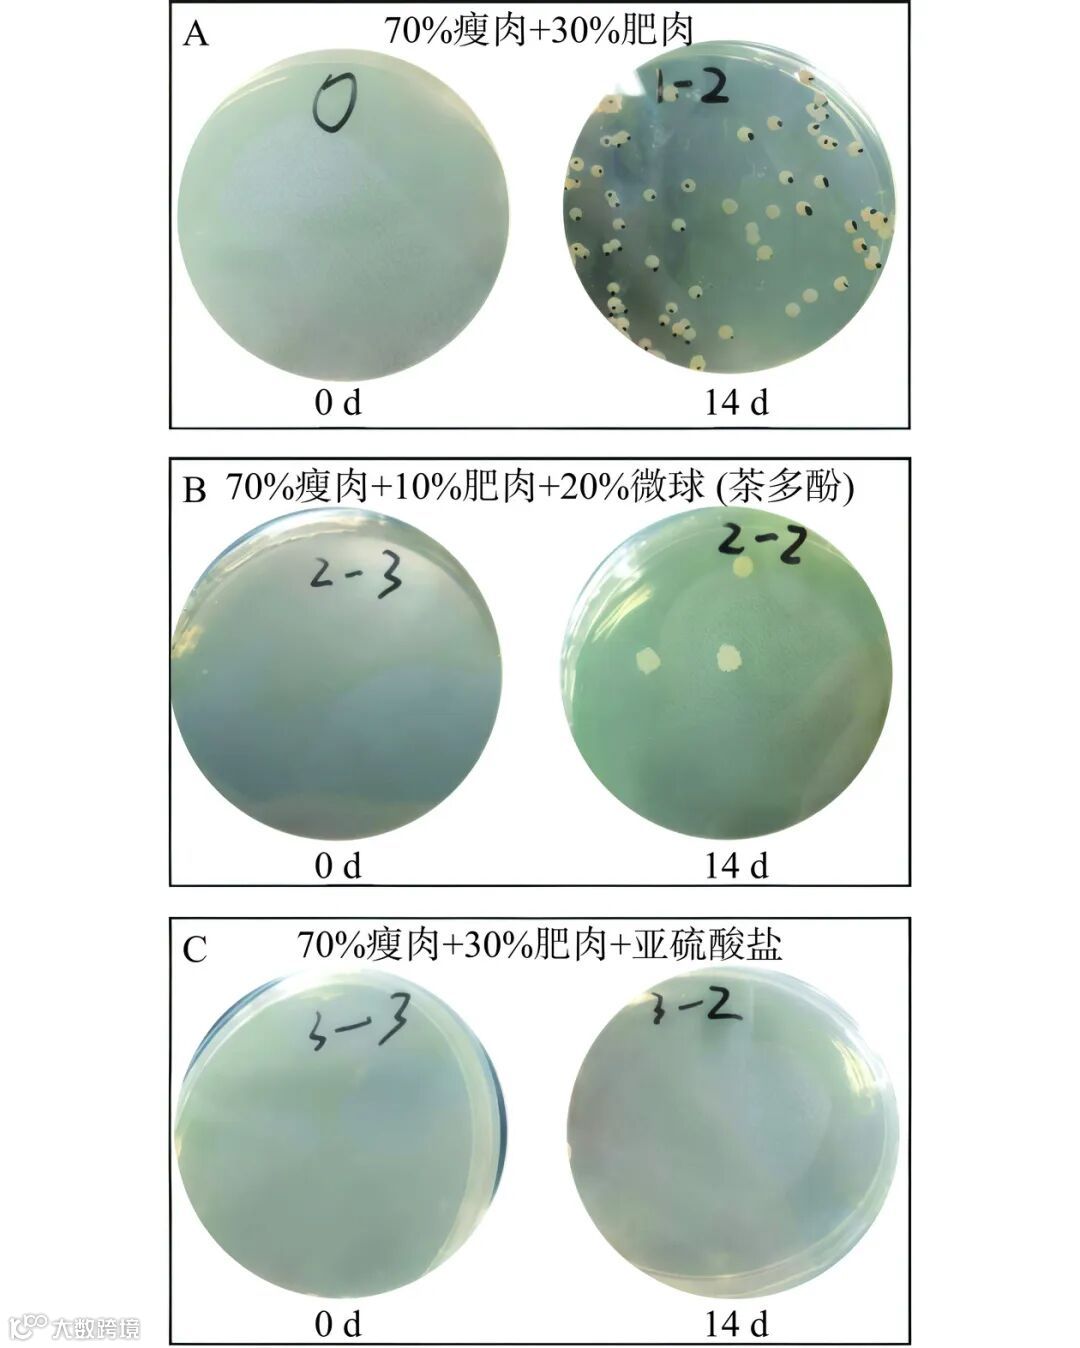

本研究旨在开发一种以茶多酚-大豆分离蛋白微球为脂肪替代物的低脂乳化香肠。本文通过 80 ℃ 热交联的方法构建了一种富含茶多酚的植物基蛋白凝胶微球,即茶多酚-大豆分离蛋白微球。借助荧光显微镜、共聚焦显微镜和扫描电镜对微球的形貌和直径进行表征;利用体外消化实验研究了模拟胃肠环境下微球中茶多酚的释放动力学;最后利用茶多酚-大豆分离蛋白微球代替脂肪制备了低脂乳化香肠,并对低脂香肠的质构、贮藏性能进行了表征,同时对低脂香肠的外观、口感、质地、风味、接受度等进行感官评价。结果表明,微球在胃液中 120 min后茶多酚释放率仅约 20%,而在肠液中释放率逐渐升至 60%,展现出良好的肠道响应性。与未添加微球的全脂香肠相比,含微球的低脂香肠在硬度、内聚性、弹性、胶粘性和咀嚼性等质构指标上无显著差异(P>0.05),且风味物质含量接近,表明其质构和风味得以有效保持。同时,低脂香肠的保质期延长约 14 d,微生物指标检测显示其菌落总数显著低于国标限值。本文所构建的植物基凝胶脂肪替代物可作为优良的脂肪替代物,用于开发低脂、健康且口感接近全脂产品的乳化香肠,在低脂食品中具有广阔的应用前景。
作为最古老且有效的食品保鲜技术,低温贮藏在维持肌肉食品、水果和蔬菜的安全及质量方面发挥着关键作用,根据贮藏环境温度的不同,现代工业中通常以冷藏(0~4 ℃)和冷冻(低于−18 ℃)两种方式来提高产品的品质稳定性。近年来,与传统肉制品相比,调理牛排因其食用方便、营养均衡等优势,越来越受到消费者的青睐。调理牛排产品通常采用冷藏或者冷冻方式进行贮运销售。传统的冷藏技术货架期较短,难以进行长线的冷链运输;此外,尽管冷冻技术可以大幅度延长货架期,但是贮藏过程中冰晶的生长/再结晶会对肌肉组织造成剧烈的机械损伤,解冻后过多的汁液损失会直接损害行业的经济效益和消费者的健康需求。因此,有必要开发新型的低温保存技术以维持食品原有的品质。
脂肪是肉制品形成良好口感与风味的重要因素。然而随着我国经济的快速发展,人均脂肪摄入量远超《中国居民膳食指南(2022)》推荐标准(0.45 g/kg 体重)。过量的脂肪摄入会增加肥胖风险,并可能诱发高血压、糖尿病、冠心病等慢性疾病,因此越来越多的消费者崇尚低热量、低脂肪的健康饮食。近年来,消费者已转向更健康的加工肉类产品,低脂肉制品的开发将是今后开发健康肉制品的热点之一。脂肪替代品是指可以发挥脂肪的部分或全部功能但卡路里较少的成分。因其具有加入食品后性质稳定、热量低、能够模拟脂肪的质构和感官特性等优点,近年来受到了学术界和产业界的关注。目前脂肪替代物可以分为以下几类:脂肪基质类(fatbased)、蛋白质基质类(protein-based)、碳水化合物基质类(carbohydrate-based)及复合型脂肪替代品(combination fat)。蛋白质基质类脂肪替代品因其在模拟脂肪口感、改善食品品质、降低热量和提供营养等方面具有显著优势而备受关注。大豆分离蛋白作为蛋白质基质类脂肪替代物的代表,其氨基酸的种类和数量配比符合人体合成蛋白质的氨基酸模式,是植物性完全蛋白,在营养价值上可以媲美动物蛋白,是人类饮食中重要的植物蛋白之一。生产每公斤大豆分离蛋白所需的土地面积和温室气体排放量均低于动物蛋白,同时大豆分离蛋白具有良好的乳化与凝聚性能,不需要任何化学修饰就可以自发地与生物活性物质结合。因此,大豆分离蛋白在满足人体营养健康需求的情况下,又兼具环保与可持续性,更符合低碳绿色的理念,已经被广泛应用于食品工业生产。
近年来,随着人们对微观尺度胶体材料研究的不断深入,多种食品胶体构成的微粒系统(microparticles delivery systems)已被用作食品中脂肪的替代物。蛋白微粒系统是指蛋白经剪切、加热、搅打等工艺制备成的凝胶微粒。已有研究团队构建出一种热交联乳清蛋白微球,用于替代人造奶油中的脂肪,该微球通过稳定油水界面形成高内相的 Pickering 乳液,提高了体系的粘弹性和假塑性。此外,蛋白微粒在油水界面还具有延缓脂肪消化的效果,可以显著减少摄入的脂肪热量。因此,蛋白凝胶球作为低脂食品脂肪替代物具有极大的应用潜力。研究发现,微粒系统还具有递送生物活性物质、修饰和构建食品微观结构、保持食品品质稳定、提供食品所需感官品质等功能。大豆分离蛋白可以以聚集形式形成纳米或微米尺度的胶体粒子,能够荷载功能因子提高其吸收利用率,是理想的功能因子递送载体。同时,大豆分离蛋白微粒系统经过剪切等处理,颗粒粒径大幅度减小,功能基团充分暴露,进一步提高了大豆分离蛋白本身的溶解性、乳化性以及持水性,从而更好地提供食品所需要的微观结构,这些暴露的功能基团以及特定空间结构为其荷载生物活性成分提供了可能。目前已有研究表明大豆分离蛋白微粒可以包埋姜黄素、叶酸和辅酶 Q10等功能性疏水因子,通过靶向递送并在特定部位响应性释放功能因子,可以有效提高功能因子的生物利用率。茶多酚是茶叶中多酚类物质的总称,包括儿茶素类、花色苷类等,其中表没食子酸儿茶素没食子酸酯(epigallocatechin gallate,EGCG)是茶多酚的主要活性成分。研究发现 EGCG 能与自由基结合形成稳定的酚羟自由基,起到清除自由基的效果,因此具有高抗氧化能力。茶多酚在抗肿瘤、抗癌变、抑制心血管疾病等方面也具有重要作用,对人体健康具有重要意义。此外,茶多酚具有强效的抗菌与杀毒作用,并且抗菌谱广,对革兰氏阳性菌、革兰氏阴性菌以及病毒都具有抑制作用。与亚硫酸盐等传统食品抗菌剂相比,茶多酚无毒副作用,对机体无刺激,并且具有天然的保健功能,已成为新型抑菌活性物质,并应用于食品行业。尽管具有多种功能性质,茶多酚在潮湿、阳光、高温等条件下极易发生氧化、聚合、缩合等反应,使其分子结构中的生理活性酚羟基变成醌,影响其功效的发挥。此外,茶多酚在口服摄入后,由于其在人体消化道环境中容易降解和代谢,且分子不易被肠道细胞吸收,导致其生物利用度较低。因此,提高其稳定性及生物利用度是应用过程中急需解决的问题。采用大豆分离蛋白微粒包埋 EGCG 从而提升其稳定性和吸收率是提升其作用效果的有效解决方法。
目前,常通过土豆淀粉、复配魔芋胶、麦芽糊精等替代脂肪,构建低脂乳化香肠,但这些方法会导致低脂香肠的口感与全脂香肠差异较大,并且营养较为单一。本文拟以大豆分离蛋白为原料设计了一种新型植物蛋白微球,一方面其可以作为脂肪替代物的基质,另一方面用微球包埋功能因子茶多酚,以部分替代防腐剂亚硫酸盐加入低脂香肠中。首先对茶多酚-大豆分离蛋白微球进行结构、包埋率、体外模拟胃肠液释放等性质表征,随后使用茶多酚-大豆分离蛋白微球作为脂肪替代物代替猪肉脂肪制备了低脂乳化香肠,并对低脂乳化香肠的质构、感官、贮藏稳定性等特性进行评价,以期生产出一种低脂、安全、兼具健康和美味的低脂香肠产品。
2.1 大豆分离蛋白微球的形貌和尺寸分布
首先对大豆分离蛋白微球表面形貌和粒径进行了表征,显微镜明场模式下可以观察到分散性良好的透明水凝胶型大豆蛋白微球(图 1A),采用共聚焦显微镜对经罗丹明 B 染色的单个微球进行观察,发现荧光分子进入内部使微球横截面显现荧光,直径在5 μm 左右(图 1B),而在扫描电镜下,微球呈现塌陷的球状结构(图 1C)。动态光散射粒径分布曲线(图 1D)表明微球的粒径分布在 1~10 μm 范围内,与荧光显微镜、共聚焦显微镜、扫描电镜图像的结果相吻合。以上结果表明通过反相乳液热交联法成功制备出了微米尺度的大豆分离蛋白凝胶微球,为包埋活性成分提供了载体基础。

图 1 大豆分离蛋白微球的形貌图像和粒径分布曲线
Fig.1 Morphology image and particle size distribution curve of soybean protein microspheres
注:A.荧光显微镜图像;B.共聚焦显微镜图像;C.扫描电镜图像;D.粒径分布曲线。
2.2 大豆分离蛋白微球包埋茶多酚的理化性质表征
2.2.1 大豆分离蛋白微球包埋茶多酚前后的电势变化
对大豆分离蛋白微球以及大豆分离蛋白微球包埋茶多酚前后的电势进行测定(表 3),测得大豆分离蛋白微球电势为-49.65±0.11 mV,而包埋茶多酚之后电势为-43.03±0.12 mV。结果显示包埋茶多酚前后电势变化不显著,这表明茶多酚可能通过疏水相互作用结合于大豆分离蛋白微球内部,因此微球的表面电势并没有发生较大改变。
表 3 大豆分离蛋白微球包埋茶多酚前后的电势
Table 3 Potential before and after encapsulation of tea polyphenols by soybean protein microspheres

2.2.2 大豆分离蛋白微球包埋茶多酚的包埋率以及在模拟胃肠液中的释放率
为进一步探究大豆分离蛋白微球的包埋能力以及茶多酚的体内释放效果,测定了茶多酚的包埋率以及包埋茶多酚的大豆分离蛋白微球在模拟胃肠液的释放率。通过萃取法测定的大豆分离蛋白微球包埋茶多酚的包埋率为 81.3%,该结果表明大豆分离蛋白微球包埋茶多酚的能力良好,该微球的制备与应用具有较强的可行性。从模拟胃液的释放曲线可以看出,包埋茶多酚的大豆分离蛋白微球在胃液中停留 120 min 后,茶多酚的释放率只有 20% 左右(图 2A),这是由于大豆分离蛋白微球在胃酸或胃蛋白酶条件下仅轻微水解,释放出少量茶多酚,说明微球可以负载大部分茶多酚经胃消化后抵达肠道。在肠液中,大豆分离蛋白微球中的茶多酚随着时间的延长逐渐释放,释放率从 20% 缓慢升高到 60%(图 2B),表明微球作为载体起到了肠道响应性释放的效果,在肠道中持续缓慢地释放,有利于提高功能因子在肠道的吸收利用。

图 2 大豆分离蛋白微球包埋茶多酚在模拟胃肠液中的释放曲线
Fig.2 Release curve of tea polyphenols embedded in soybean protein microspheres in simulated gastrointestinal fluid
注:A.模拟胃液;B.模拟肠液。
2.3 茶多酚-大豆分离蛋白低脂乳化香肠的表征
2.3.1 大豆分离蛋白低脂乳化香肠成品及微观图像
接下来测定了大豆蛋白微球在肉肠中发挥脂肪替代作用的能力。按照不同的肥瘦比与微球添加量制作 4 种不同质量比(瘦肉:肥肉:微球)的大豆分离蛋白低脂乳化香肠,其成品照片如图 3A 所示。随着脂肪含量降低,微球含量增加,香肠横截面上的白色脂肪颗粒逐渐减少,当脂肪被微球完全替代时,白色脂肪颗粒减少最为显著,横截面主要呈粉红色。总的而言,4 种香肠在外观和色泽上差异不明显,这表明用微球替代脂肪并不会显著影响香肠的外观和色泽。选择含有瘦肉、肥肉与微球的香肠进行微观分析,将最低微球添加量的处理组香肠(70% 瘦肉+20% 肥肉+10% 微球)切片,瘦肉、脂肪、微球分别用固绿、尼罗红、Cy3 染色,使肌肉纤维呈现绿色,脂肪呈现红色,微球呈现黄色。从图 3B 可以看出,绿色的肌肉纤维中夹杂少许红色脂肪,而黄色的蛋白微球分布于香肠中,这证实了在最低微球添加量的处理组,大豆分离蛋白微球添加到香肠中后仍可以保持其形态,并均匀分布在香肠中。这是由于大豆分离蛋白微球的粒径很小,并且单个微球呈圆球状,水分散性好,在与香肠混合的过程中,可以均匀分散地浸入香肠的肌肉组织中。

图 3 大豆分离蛋白低脂乳化香肠成品及微观图像
Fig.3 Finished product and microscopic image of soy protein low-fat emulsified sausage
注:A.香肠成品图像;B.共聚焦显微镜图像(肌肉纤维呈现绿色,脂肪呈现红色,微球呈现黄色)。
2.3.2 质构分析
对四种不同配比的添加大豆分离蛋白微球的低脂乳化香肠进行质构表征,从硬度、弹性、胶粘性和咀嚼性等方面考察添加微球对香肠质构的影响。由表 4 可知,与未添加微球的全脂组(A 组)相比,随着微球添加量的增加(B、C、D 组),香肠的硬度、内聚性、弹性、胶粘性、咀嚼性无显著变化(P>0.05),表明添加茶多酚-大豆分离蛋白微球的低脂香肠保留了高脂香肠的质构特性。这种现象可能是由于外源添加的乳化型大豆分离蛋白微球颗粒小,可以有效填充肌纤维蛋白网络中的空腔,从而促进形成凝胶的致密结构。
表 4 大豆分离蛋白微球替代不同比例脂肪所制作的香肠的质构结果
Table 4 Texture results of sausages prepared by replacing fat with different proportions of soy protein microspheres

2.3.3 感官评价
从香肠的外观、口感、质地、风味、色泽以及个人接受度六个方面对香肠进行感官评价,挑选了 10 名感官评定经验丰富的工作人员对香肠成品进行感官品评并打分。从感官评分结果(表 5)可以看出,使用大豆分离蛋白微球替代脂肪的香肠(B、C、D 组)与全脂组的香肠(A 组)在外观、质地、色泽方面差异不显著,而在口感、风味方面,D 组(70% 瘦肉+30% 微球)略低,这可能是由于大豆蛋白微球全部替代脂肪后,缺少了脂肪独有的风味。B、C 组(70% 瘦肉+20% 肥肉+10% 微球、70% 瘦肉+10% 肥肉+20% 微球)的各项评分与 A 组(70% 瘦肉+30% 肥肉)较为接近,说明用大豆蛋白微球部分替代脂肪得到的低脂香肠具有与全脂香肠相近的风味和口感。虽然大豆分离蛋白微球的添加可以保留高脂香肠的质构特性,但是如果脂肪被完全替代,低脂香肠就可能因缺乏脂肪氧化、脂肪水解等反应而导致呈味物质减少,从而丧失脂肪独有的风味。因此,采用大豆分离蛋白微球部分替代脂肪可能是较优策略。
表 5 感官评分结果
Table 5 Sensory score results

2.3.4 微生物评价
2.3.4.1 大豆分离蛋白低脂乳化香肠成品菌落总数及大肠菌群
以菌落总数和大肠菌群数为指标对香肠的微生物水平进行评价。由表 6 可知,大豆分离蛋白低脂乳化香肠内部的菌落总数远低于国标 GB4789.2-2016 中所规定的 5×104 CFU/g,并且所有样品均未检出大肠菌群。结果表明大豆分离蛋白低脂香肠微生物水平符合国标标准,并且脂肪替代程度对成品香肠的菌落总数和大肠菌群的影响较小。这是由于香肠制作过程中的蒸煮步骤,不仅可以熟化香肠,而且其热穿透能力对香肠中的微生物有明显的杀灭作用,使成品香肠符合食品安全要求。
表 6 低脂乳化香肠成品菌落总数及大肠菌群检测结果
Table 6 Total bacterial count and coliform test results of finished low-fat emulsified sausages

2.3.4.2 大豆分离蛋白低脂乳化香肠贮藏期间的菌落数量变化
为探究茶多酚对大豆分离蛋白低脂乳化香肠的抑菌作用,对全脂组、低脂组、全脂组+亚硫酸盐三组香肠进行贮藏实验,通过平板计数观察大豆分离蛋白低脂乳化香肠贮藏期间的菌落数量变化。结果表明,在不添加防腐剂情况下,全脂组(70% 瘦肉+30% 肥肉)14 d 后菌落数量显著增加(图 4A),而添加了包埋茶多酚的大豆分离蛋白微球的低脂组(70% 瘦肉+10% 肥肉+20% 微球(茶多酚))14 d 后菌落数量依然保持较低的水平(图 4B),添加了防腐剂亚硫酸盐(70% 瘦肉+30% 肥肉+亚硫酸盐(与茶多酚浓度一致) )的全脂组同样有显著抑菌效果(图 4C),不同组别的香肠随时间延长的菌落数目变化折线图(图 5)同样反映了这一趋势,因此,茶多酚在一定程度上能够替代亚硫酸盐。在外观上,14 d后不添加防腐剂的全脂组香肠有发酸发臭、渗液现象,而添加茶多酚的低脂组香肠以及添加防腐剂亚硫酸盐的全脂组香肠具有正常气味,无渗液现象。这说明天然活性成分茶多酚具有一定的抑菌作用,其抑菌的主要机理可能是茶多酚可以阻碍细菌蛋白质的正常表达,影响细菌细胞结构的形成以及正常生理功能,从而达到对细菌生长的抑制作用。茶多酚作为天然防腐剂,添加到香肠当中既能延长香肠的保质期又能提高香肠的营养和健康价值,具有良好的应用前景。
图 4 贮藏期间香肠菌落的变化情况
Fig.4 Changes in the colonies of sausages during storage
注 :A.全 脂 组 ( 70% 瘦 肉 +30% 肥 肉 ) ;B.低 脂 组 ( 70% 瘦肉+10% 肥肉+20% 微球(茶多酚) ) ;C.全脂组+亚硫酸盐(70% 瘦肉+30% 肥肉+亚硫酸盐)。

Fig.5 Changes of the total number of colonies in sausages during storage
注:全脂组(70% 瘦肉+30% 肥肉);低脂组(70% 瘦肉+10% 肥肉 +20% 微 球 ( 茶 多 酚 ) ) ;全 脂 组 +亚 硫 酸 盐 ( 70% 瘦肉+30% 肥肉+亚硫酸盐)。
本文通过热交联制备的植物基大豆分离蛋白微球直径约为 5 μm,呈凝胶球形,茶多酚包埋率达81.3%。模拟胃肠液释放实验结果表明茶多酚-大豆分离蛋白微球具有肠道响应性释放特性,且在肠液中缓慢释放。在低脂乳化香肠的制备过程中,将茶多酚-大豆分离蛋白微球按照不同添加比例加入低脂香肠中替代脂肪,结果显示随着微球添加率的上升脂肪颗粒明显减少,香肠仍能保持粉红的色泽与紧实的质构,并且在感官评价中整体接受度与全脂香肠持平。茶多酚-大豆分离蛋白微球在抑菌方面有明显的优势,能够抑制贮藏期内香肠的腐败变质,一定程度替代亚硫酸盐。实验结果表明,添加 30% 的微球低脂香肠虽然能够模拟全脂香肠的外观与质构,但其风味仍与全脂香肠存在一定差距。相比之下,保留10% 脂肪、添加 20% 微球的低脂香肠能够在取代脂肪的同时保留香肠的风味,是一种更优的脂肪替代方法。总之,大豆分离蛋白低脂乳化香肠在感官评价、营养健康、抑菌效果方面优势突出,作为低脂食品的脂肪替代物具有广阔的应用前景。未来可以优化高产率的微球产业化制备工艺,并继续探索大豆蛋白微球在其他低脂食品中的应用。
引用本文:欧阳宇桐,程星子,李卢嘉,等. 茶多酚-大豆分离蛋白微球的构建及其对低脂乳化香肠的影响[J]. 食品工业科技,2025,46(19):183−190. doi: 10.13386/j.issn1002-0306.2025050013.
Citation: OUYANG Yutong, CHENG Xingzi, LI Lujia, et al. Preparation of Tea Polyphenol-Soy Protein Isolate Microspheres and Their Effects on Low-fat Emulsified Sausage[J]. Science and Technology of Food Industry, 2025, 46(19): 183−190. (in Chinese with English abstract). doi: 10.13386/j.issn1002-0306.2025050013.

李媛,教授,博士生导师,入选国家级高层次人才支持计划、中国科协“强国青年科学家”、北京市青年拔尖人才计划和北京市科技新星。致力于“食品功能因子的精准靶向递送”学科交叉研究方向,基于食品大分子构建了一系列肠道靶向和微环境响应性释放的先进载体,利用载体技术实现了功能因子的体外稳态加工,体内精准递送和活性协同增效,最终达到了食品精准营养干预的目标。获霍英东教育基金会高等学校“青年科学奖”、英国乳业协会“Ernest Mann”青年科学家奖和中国农学会“青年科技奖”。主持国家自然科学基金 5 项,企业教授工作站和横向课题 5 项等。近5年以通讯作者在 Nature Sustainability, Science Advances, Advanced Functional Materials, ACS Nano, Nano Letters等发表高水平论文,其中 IF>15 的 12篇,Nature Index 收录 5 篇,封面论文 8 篇,总他引 2000 多次。授权中国发明专利 12 项。获教育部高等学校科学研究优秀成果奖“自然科学二等奖”(1/8),中国乳制品工业协会“技术发明一等奖”(1/6)和中国商业联合会“科技进步二等奖”(1/15)。
或登录www.spgykj.com阅览全文。
群聊:食品工业科技作者群

我刊正式组建微信作者群,为作者提供更多的学术与论文资讯,如需进群,请联系刘老师(微信:上方二维码,电话:87244117-8062)。
《食品工业科技》具有以上论文在全世界范围内的复制权、发行权、翻译权、汇编权、广播权、表演权、信息网络传播权、转许可权及以上权利的邻接权,且作者已授权期刊同论文著作权保护期。如需转载,可联系《食品工业科技》编辑部010-87244116,或直接在文末撰写转载来源。